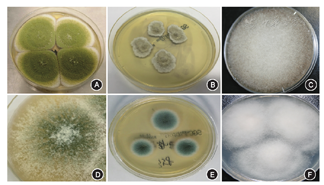

建立并评价实验室自行研发的丝状真菌质谱鉴定前处理方法的可行性。
复苏2014年1月至2016年12月北京同仁医院菌库中380株丝状真菌菌株,沙保弱葡萄糖琼脂平板(SDA)28 ℃培养至成熟状态,同时使用Bruker仪器推荐的垂直旋转法培养和本实验室研发的"水平震荡法"培养至足量菌落。3种方法培养菌株均采用"改良磁珠提取法"提取蛋白行质谱鉴定。
380株真菌菌株,使用SDA培养时间需要3~10 d,鉴定到种和属的比率分别是47%和81%;使用Bruker仪器推荐方法培养时间需要5~7 d,鉴定到种和属的比率分别是76%和94%;"水平震荡法"培养时间只需1~2 d,鉴定到种和属的比率分别是96%和99%。"水平震荡法"和SDA培养法比较,差异有统计学意义(χ2=39.026,P<0.01),和仪器推荐的方法比较,差异有统计学意义(χ2=11.310,P<0.01)。
本实验室研发的"水平震荡法"和"改良磁珠提取法"优于仪器推荐的方法和SDA培养鉴定方法,可以应用到临床。

版权归中华医学会所有。
未经授权,不得转载、摘编本刊文章,不得使用本刊的版式设计。
除非特别声明,本刊刊出的所有文章不代表中华医学会和本刊编委会的观点。
基质辅助激光解析电离飞行时间质谱技术(MALDI-TOF-MS)作为近几年快速发展的新技术,其在普通细菌、分支杆菌、厌氧菌、酵母样真菌、奴卡菌和放线菌鉴定,阳性血培养瓶快速鉴定、尿液标本快速检测、细菌耐药性和同源性分析方面已经凸显了明显的优势[1,2,3,4,5,6,7,8,9,10,11],但在丝状真菌的检测上目前还存在着重复性差、准确率低、操作方法不统一、结果可比性差的问题。本研究通过近3年的摸索和条件不断优化,探讨使用本室自行研发的新方法运用MALDI-TOF-MS快速准确鉴定丝状真菌的可行性。
380株实验菌株全部来自我院眼科、耳鼻喉头颈外科、呼吸科和风湿免疫科患者2014年1月至2016年12月留取的丝状真菌菌株,留取前全部经培养形态学镜检[12,13,14]进行明确鉴定,部分镜下形态无法区分的使用序列测定法[15]予以确认。(1)曲霉属:烟曲霉50株、米曲霉5株、黄曲霉50株、土曲霉30株、构巢曲霉30株、杂色曲霉30株、黑曲霉50株;(2)暗色真菌:链格孢霉20株、单孢瓶霉3株;(3)青霉菌属:产黄青霉菌10株;(4)接合菌属:米根霉8株、葡枝根霉1株;(5)镰刀菌属:串珠镰刀菌10株、茄病镰刀菌40株、变红镰刀菌2株;(6)木霉属:康宁木霉1株;(7)尖端赛多孢子菌20株、普通裂褶菌20株。标准菌株黄曲霉(CGMCC 3.1398)和构巢曲霉(CGMCC 3.1322)作为质谱鉴定和测序的阳性对照。
沙保弱葡萄糖琼脂平板(SDA,法国梅里埃公司)、液体沙保弱培养基(天津市金章科技发展有限公司),氧化锆/硅胶珠(11079101z,美国BioSpec公司,简称磁珠),甲酸、乙腈、α-氰基-4-羟基肉桂酸(HCCA,美国Sigma公司),定标液(德国Bruker公司),旋转培养仪(海门市其林贝尔仪器制造有限公司),空气摇床(太仓市实验设备厂),质谱仪(德国bruker公司)。
全部菌株均采用SDA平板28 ℃静置培养,根据不同菌株的生长速度培养时间为3~10 d不等。待培养出成熟孢子后进行乳酸酚棉兰染色后显微镜下再次观察菌株,以确认留取菌株鉴定无误后进行后续质谱鉴定。同时按照仪器操作要求转种2管液体沙保弱培养基,分别于28 ℃旋转培养仪120次/min垂直旋转培养和本实验室自行研发的恒温空气摇床28 ℃ 120次/min水平震荡培养,直至生长出足够多的菌丝为止。培养时间为1~7 d,以观察哪种培养基和培养方式、培养时间更适合质谱鉴定。垂直旋转培养方式、空气摇床和水平震荡培养方式如图1,图2,图3所示:传统的空气摇床是把培养管直接插入图2摇床的插孔中震荡;水平震荡培养是在摇床的插孔上方放入1个托盘,将托盘四周固定,震荡方向就由原来的垂直震荡变成水平震荡。


吸取上述3种培养方式的上清液1 μl添加到MALDI-TOF-MS靶板上,在室温下自然晾干。在上述样品点上覆盖1 μl α-氰基-4-羟基肉桂酸(HCCA)基质溶液在室温下自然晾干。同时点1 μl标准品在质谱仪靶板上,覆盖1 μl HCCA基质溶液在室温下自然晾干。即可上机质谱鉴定。质谱仪的工作条件(激光频率60 Hz ,每个样品点设激光随机射击100个点,每次射击100次,累加300次,采集范围2 000~20 000 Da ),待定标通过后,既可测定靶板上待测样品。结果分值≥1.700可鉴定到属,≥2.000可鉴定到种。
通过SPSS 22.0软件进行统计学分析。二分类变量及无序多分类变量使用χ2检验,理论频数<5时使用似然比χ2值,<1时使用Fisher精确概率法。P<0.05为差异有统计学意义。
SDA上菌落生长较慢,产孢量较多;垂直旋转培养方式生长较慢,菌落容易缠绕成团;水平震荡培养方式生长较快,菌落颗粒细密;见图5,图6,图7。






使用水平震荡法质谱鉴定效果明显优于SDA培养方法和仪器推荐的垂直旋转法。曲霉菌属除1株构巢曲霉、2株杂色曲霉、5株黑曲霉没有准确鉴定到种外,其余均鉴定到种;暗色真菌中的链格孢霉、接合菌属、尖端赛多孢子菌、普通裂褶菌均能准确鉴定到种;80%的青霉菌属鉴定到种,单孢瓶霉、变红镰刀菌和康宁木霉因收集菌株数量较少,菌库中可比对的菌株数量不多而鉴定到属,具体结果见表1。水平震荡法鉴定到种的准确率显著高于SDA培养法及垂直旋转法(χ2=39.026、11.310,均P<0.01)。

380株丝状真菌不同培养方法质谱鉴定结果比较[株(%)]
380株丝状真菌不同培养方法质谱鉴定结果比较[株(%)]
| 菌名 | 株数 | SDA培养5~10 d | 沙保弱液体培养基垂直旋转法培养5 d | 沙保弱液体培养基水平震荡法培养2 d | |||
|---|---|---|---|---|---|---|---|
| 种 | 属 | 种 | 属 | 种 | 属 | ||
| 菌株总数 | 380 | 177(47) | 306(81) | 290(76) | 358(94) | 365(96) | 379(99) |
| 烟曲霉 | 50 | 35(70) | 50(100) | 45(90) | 50(100) | 50(100) | 50(100) |
| 黄曲霉 | 50 | 30(60) | 50(100) | 45(90) | 50(100) | 50(100) | 50(100) |
| 米曲霉 | 5 | 2(40) | 4(80) | 3(60) | 4(80) | 5(100) | 5(100) |
| 土曲霉 | 30 | 15(50) | 25(83) | 23(77) | 30(100) | 30(100) | 30(100) |
| 构巢曲霉 | 30 | 16(53) | 24(80) | 22(73) | 28(93) | 29(97) | 30(100) |
| 杂色曲霉 | 30 | 10(33) | 21(70) | 21(70) | 25(83) | 28(93) | 30(100) |
| 黑曲霉 | 50 | 15(30) | 32(64) | 30(60) | 45(90) | 45(90) | 50(100) |
| 链格孢霉 | 20 | 6(30) | 13(65) | 17(85) | 19(95) | 20(100) | 20(100) |
| 单孢瓶霉 | 3 | 0(0) | 2(67) | 1(33) | 2(67) | 1(33) | 3(100) |
| 产黄青霉菌 | 10 | 4(40) | 8(80) | 6(60) | 10(100) | 8(80) | 10(100) |
| 米根霉 | 8 | 4(50) | 8(100) | 5(63) | 8(100) | 8(100) | 8(100) |
| 葡枝根霉 | 1 | 0(0) | 1(100) | 0(0) | 1(100) | 1(100) | 1(100) |
| 串珠镰刀菌 | 10 | 4(40) | 7(70) | 6(60) | 9(90) | 10(100) | 10(100) |
| 茄病镰刀菌 | 40 | 16(40) | 27(68) | 30(75) | 35(88) | 40(100) | 40(100) |
| 变红镰刀菌 | 2 | 0(0) | 1(50) | 0(0) | 1(50) | 0(0) | 1(50) |
| 康宁木霉 | 1 | 0(0) | 0(0) | 0(0) | 1(100) | 0(0) | 1(100) |
| 尖端赛多孢子菌 | 20 | 10(50) | 15(75) | 18(90) | 20(100) | 20(100) | 20(100) |
| 普通裂褶菌 | 20 | 10(50) | 18(90) | 18(90) | 20(100) | 20(100) | 20(100) |
注:SDA:沙保弱葡萄糖琼脂平板
临床上真菌的鉴定主要依靠培养后形态观察或分子序列测定[16]。但培养周期较长,容易污染,形态观察对人员的技术能力和经验的依赖程度高;一些形态相近或近几年新发的菌株无法准确鉴定。分子序列分析虽然是检测的金标准,但测定费时费力费钱,不太适合临床常规使用。MALDI-TOF-MS作为近年来快速发展的技术,其在临床病原微生物的鉴定方面快速、准确、价廉、无需依赖人员技术能力的特点已越来越多的被临床实验室所认可。
但质谱技术在丝状真菌的鉴定方面国内还处于探索阶段[17,18,19,20]。一是国内很多家医院缺乏丝状真菌的病原,这方面的运用经验较少;二是由于丝状真菌的结构比细菌复杂,其蛋白提取质量直接影响质谱鉴定效果;真菌培养和蛋白提取需要标准化。三是病原真菌的参考质谱数据库数量较少,很多临床菌株无法给出鉴定结果。针对这些问题,本研究尝试用不同的真菌培养基如SDA、实验室开发的液体沙保弱培养基水平震荡法和仪器推荐的方法培养真菌。然后使用实验室研发的"改良磁珠提取法"提取真菌蛋白,以观察不同的培养基、不同的培养方式和培养时间、蛋白提取方法对后续质谱鉴定的影响。
实验结果发现在固体培养基上真菌气生现象明显,产孢量大,提取蛋白时不易提取,孢子壁不易溶解,质谱鉴定率偏低,鉴定到种的比率是47%,到属的比率为81%。这和文献报道使用固体培养基鉴定结果不一致,分析原因主要是文献中鉴定的数据库大多基于实验室自建,比对分值自然稍高[21,22]。另外Bruker公司的丝状真菌数据库基于液体培养法建立,所以质谱谱图匹配度不高[11,17,19,23]。
文献报道[18]培养时间120 h是最佳时间点,能够得到高质量的谱图。但本实验显示,从培养第2天开始检测到第10天,随着时间的延长鉴定的谱图反而减少,基质峰增多,鉴定的分值减低。另外传代次数越多质谱鉴定结果越差。经过反复摸索,使用液体水平震荡培养方式培养时间在48 h时质谱鉴定的谱图最好,鉴定的准确度最高。分析可能是真菌细胞壁组分在不同生长时期有所不同,早期主要是几丁质层和蛋白质层,成熟期则有几丁质层、蛋白质层、葡聚糖蛋白层和质层蛋白质层组成。因此随着培养时间延长细胞壁层逐渐变厚,提取蛋白时更不易破壁[24]。使用本实验室自行开发的水平震荡培养法与仪器推荐培养法相比,大大缩短了培养时间,真菌生长速度更快,且菌丝颗粒更细、水平震荡的方式不易让菌丝缠绕成团,而且空气摇床相对于质谱仪器推荐的旋转培养仪价格低廉、操作简单,容易普及。
使用实验室研发的"水平震荡培养法"配合"改良磁珠提取法"提取蛋白[25],大大缩短了提取时间、提高了提取效率,容易标准化,经过磁珠提取的质谱峰图丰度高,基质峰少,质谱鉴定分值大部分都在2.000以上。质谱准确鉴定到种的比率由76%上升到96%,鉴定到属的比例由94%上升到99%,比文献报道的74%(种)和94%(属)要高[26]。与SDA培养方法和仪器推荐的方法比较差异有统计学意义。只有1例变红镰刀菌和1例康宁木霉因数据库可比对数据少而只鉴定到属,这些可以通过积累菌株后自建数据库来解决鉴定分值低的问题。